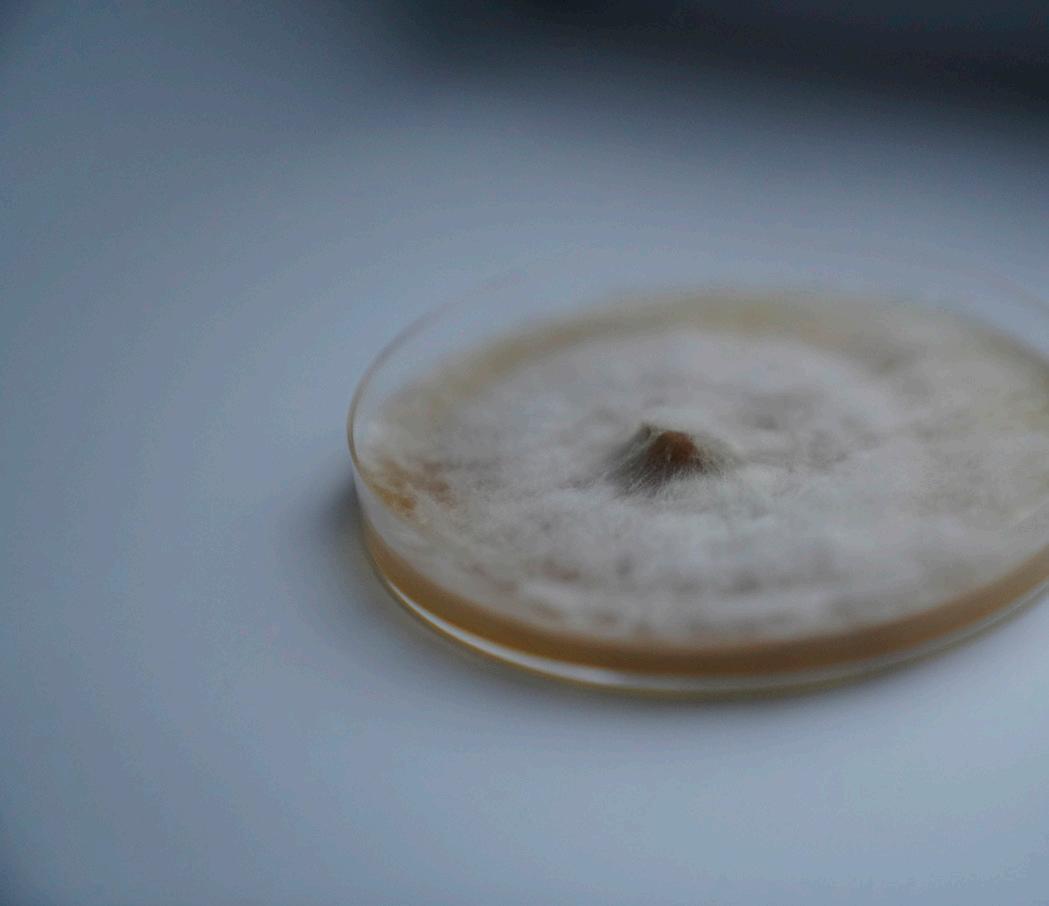

cohabitation with the living



After several months of research and inspiration from artists and designers working with mycelium abroad, the lack of resources prevented me from taking the step towards materialization and experimentation. I brought this desire to explore to Montreal in the hope of finally tackling this material and making something tangible out of it. The possibility of failure in the face of so many experiments already done by experienced individuals, and the lack of time prevented me from taking the first step on the matter.
Attracted by all that is living, this semester also pushed me towards other materials coming from the living within the framework of other projects, such as the invasive eurasian water milfoil and the kombucha leather. I am therefore facing several projects at the same time and too many possibilities. At this point I realized that there was one element that I perceived as a problem rather than a constraint in my projects and that blocked my creativity; time.
Time is what I lack on a daily basis to achieve everything I want to do. Time is what is missing to allow people to slow down and reconnect to the earth. Time is what has allowed all those I aspire to achieve great things. Time is what allowed me to discover in my studies what drives me to create every day. Time is what allows nature to regenerate and to have a cycle that provides nutrients for the next ones to be born in the same environment. Time has been molded subjectively by man and it is also what he seeks to master in order to conquer the living world. Co-designing with nature, therefore, requires re-evaluating time, letting nature reclaim its organic rhythm and being inspired by this very notion of taking the time.
I therefore decided to change my perception of this research and creation. My first idea to create a mycelium growth kit to facilitate the access to the possibility of biomaterial development to other designers was met with a feeling of failure. Multiple companies have already developed this kind of kit on the market, and yet mycelium remains an intimidating material for most students to work with. The idea then came to me to experiment with different substrates local to the urban environment of Montreal, an idea that I keep in mind. However, I still had a certain blocking reflex to experiment and a lack of understanding of the material. So I had to approach the material in a different way to become familiar with it. Photography, a medium that is very present in my practice, seemed to me to be the best approach.

sensing the living before co-creating with it
steps the three steps were therefore simple:
1 2 3
Purchase of petri dishes, mycelium in syringe, agar-agar, innoculate them.

Wait and observe the growth.
Create multimedia content for archiving the growth process.
The inoculation of the petri dishes was more complicated than I had anticipated. Not being able to work in the Lab at my disposal because of the possible contamination of mycelium spores, I decided to do it at home. Not having all the equipment available in a lab, I was missing tools to sterilize adequately the petri dishes and the preparation of agar-agar. Once inoculated, with Blue Oyster and Elm Oyster mycelium, I placed the petri dishes in a cupboard in my kitchen, to ensure a certain ambiant temperature.
The stage of mycelium growth was a great disappointment. Inoculated on November 15, the days passed and hardly any spots appeared. I therefore decided to inoculate four more petri on November 25, but this time by gently applying several drops of mycelium in each one, taking care to inoculate the whole surface of the petri. To improve growth, I decided to leave them on the heater with water containers as an in-between. This way I gave them humidity and heat. However, I noticed that even after my improvements, only a few spots appeared.


Nature, in its great strength, is always adapting to new species, new climates or new problems. I didn’t stop there and decided to call on the community for help. I asked Joelle Collin, a Master’s student at Concordia who did a project on the disintegration of natural and petrochemical fibers by mycelium, to have access to her production excess. I inherited a block of mycelium that had spread between the fibers of a mixture of sawdust and soy husks. The two months old growth was sufficient to observe the colonization of this one on such a small territory.



Mycelium colonization in a petri always intrigued me, so I reached out to the mycology community, and was able to access a petri of Wood Blewit Mushrooms, inoculated in mid September. We can see a central colonization, creating around the center, a small moss going from beige to white in a certain lightness. As amazing as it is, this little world could be created because of the perfect conditions and time. As small as it is, it represents an infinite possibility of connection, growth and reproduction.

The slowness that the process required and the sensibility that it brought me, is two necessary assets in an alternative future utopia in contradiction to the obsession of growth in our present days. The cohabitation of the space between the mycelium in its restricted ecosystem and my own ecosystem which is my domestic space made me think about a possible sensory experience. The book Queer Phenomenology: Orientations, Objects, Others from Sarah Amhed, made me recognize my desire to share my sensibility with the mycelium. Considering the subject as an open circuit between perceiving our body in this world, the co-habitation of the living should be felt. Playing with this limitation between our bodies and our skin that connects us to everything outside of us and even what it contains. Our body becomes present in a certain environment with surfaces, boundaries and demonstrate the limits of what we can do. To create a deeper relationship with the living as I have experienced, the intimacy of touch becomes necessary, and in recent years this sense was restricted. The interdiction of the sensory in a sanitized environment has deformed our approach to the world, therefore my desire to recreate these connections is very strong.

My process of reflection on my methodology for this research and creation project, came down to countering the need in an academic environment first and in professional life afterwards, to produce. As Jane Bennett explains clearly in her book Vibrant Matter: A Political Ecology of Things: «Promote greener forms of human culture & more attentive encounters between people materialities and thing materialities». The mycelium itself and the fungi world exist
without us and do not need us to grow in nature. The human who has for centuries destroyed the earth, cultivated a fantasy of conquering the world and consuming it without limit, prevents us from detecting through the senses the nameless non-human power that circulates around our bodies and in our bodies. The materiality of mycelium itself in its beauty and presence in an environment calls for our attentiveness and respect.

This research has made me want to extend this independent study into the next semester. Now that I have taken the time to approach the material little by little and try to understand it, I would love to share the senses that have been awakened during my research. I would like to establish an intimate contact between the mycelium and the human by experiencing the matter through several senses. Therefore, this semester I focused on the visual, which could be further developed. Smell, taste and touch would also be part of the sensory experience. Several small areas would be deployed in one location so that the human would gradually become familiar with this world one sense at a time. Thus, I began the process by extracting the scent from the blue oyster mycelium block with a handmade distillation method. The experimentation, far from being complete, allowed me to unfold ideas in discussion with Andrée Uranga, about the experience of the living.





Amhed, Sarah. Queer Phenomenology: Orientations, Objects, Others. Duke University Press, 2006.
Auger, James. (2013). Speculative Design: Crafting the Speculation. Digital Creativity. 24. 10.1080/14626268.2013.767276.
Bennett, Jane. “The Force of Things: Steps toward an Ecology of Matter.” Political Theory, vol. 32, no. 3, 2004, pp. 347–72. JSTOR, http://www. jstor.org/stable/4148158. Accessed 20 november. 2022.
Chauvirey, Théo (2018) Matériaux à base de mycélium en guise de substitut au plastique dans le design d’intérieur des véhicules de transport en commun : vers un métro inspiré par la nature. Masters thesis, Concordia University.
Dias, Jessica. KickStart Your Myco-Culture. https://issuu.com/nat_arc/ docs/myceliumfabtextiles , october 31 2019 (consulted october 2022).
Dunne, Anthony and Fiona Raby. Speculative Everything: Design, Fiction, and Social Dreaming. The MIT Press, 2013.
https://www.youtube.com/watch?v=cMfhsrxp76c&ab_ channel=CompanyNewHeroes
https://www.netflix.com/search?q=fantastic&jbv=81183477